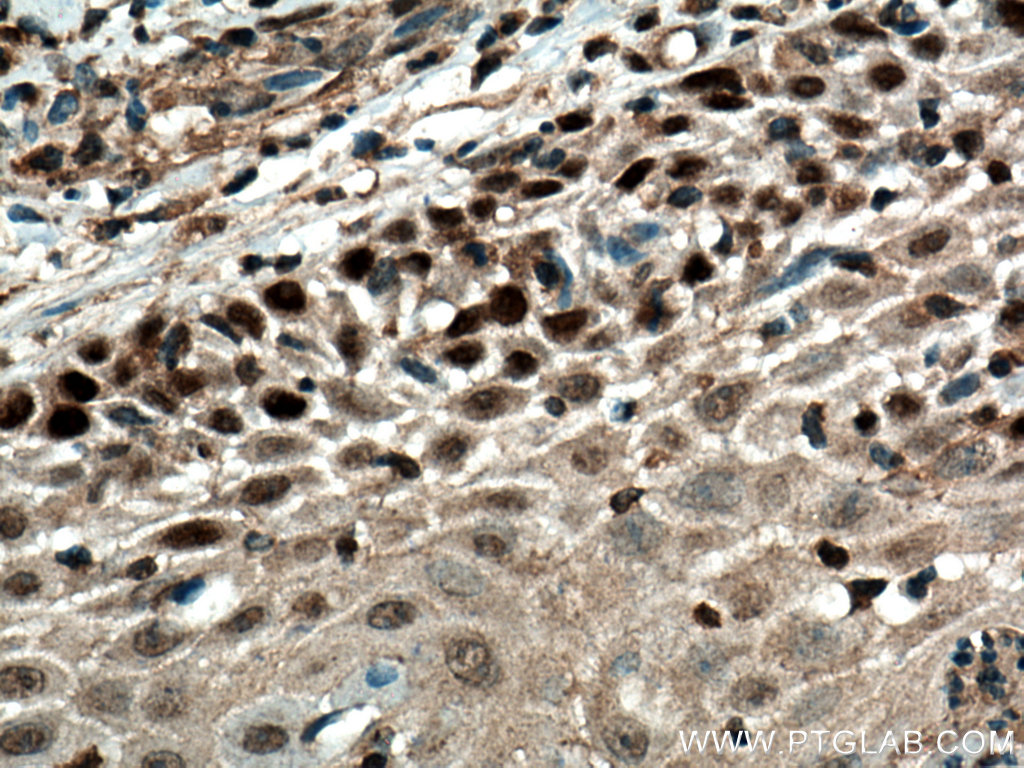

验证数据展示
经过测试的应用
| Positive WB detected in | HepG2 cells, HEK-293 cells, MCF-7 cells, human brain tissue |
| Positive IP detected in | HepG2 cells |
| Positive IHC detected in | human skin cancer tissue, human colon cancer tissue Note: suggested antigen retrieval with TE buffer pH 9.0; (*) Alternatively, antigen retrieval may be performed with citrate buffer pH 6.0 |
| Positive IF/ICC detected in | HeLa cells |
推荐稀释比
| 应用 | 推荐稀释比 |
|---|---|
| Western Blot (WB) | WB : 1:1000-1:4000 |
| Immunoprecipitation (IP) | IP : 0.5-4.0 ug for 1.0-3.0 mg of total protein lysate |
| Immunohistochemistry (IHC) | IHC : 1:50-1:500 |
| Immunofluorescence (IF)/ICC | IF/ICC : 1:50-1:500 |
| It is recommended that this reagent should be titrated in each testing system to obtain optimal results. | |
| Sample-dependent, Check data in validation data gallery. | |
产品信息
55290-1-AP targets FBXW7 in WB, IHC, IF/ICC, IP, ELISA applications and shows reactivity with human samples.
| 经测试应用 | WB, IHC, IF/ICC, IP, ELISA Application Description |
| 文献引用应用 | WB, IP |
| 经测试反应性 | human |
| 文献引用反应性 | human, mouse, rat |
| 免疫原 |
Peptide 种属同源性预测 |
| 宿主/亚型 | Rabbit / IgG |
| 抗体类别 | Polyclonal |
| 产品类型 | Antibody |
| 全称 | F-box and WD repeat domain containing 7 |
| 别名 | CDC4, F-box and WD-40 domain-containing protein 7, F-box protein FBX30, F-box/WD repeat-containing protein 7, FBW7 |
| 计算分子量 | 80 kDa |
| 观测分子量 | 100-110 kDa, 66-75 kDa |
| GenBank蛋白编号 | NM_018315 |
| 基因名称 | FBXW7 |
| Gene ID (NCBI) | 55294 |
| RRID | AB_2881300 |
| 偶联类型 | Unconjugated |
| 形式 | Liquid |
| 纯化方式 | Antigen affinity purification |
| UNIPROT ID | Q969H0 |
| 储存缓冲液 | PBS with 0.02% sodium azide and 50% glycerol, pH 7.3. |
| 储存条件 | Store at -20°C. Stable for one year after shipment. Aliquoting is unnecessary for -20oC storage. |
背景介绍
FBXW7, also named as FBW7, FBX30, SEL10 and hAgo, is a substrate recognition component of a SCF (SKP1-CUL1-F-box protein) E3 ubiquitin-protein ligase complex which mediates the ubiquitination and subsequent proteasomal degradation of target proteins. It probably recognizes and binds to phosphorylated target proteins. FBXW7 is involved in the degradation of cyclin-E, MYC, NOTCH1 released notch intracellular domain (NICD), and probably PSEN1. FBXW7 is a general tumor suppressor in human cancer (PMID: 17909001). FBXW7 has 3 isoforms (α/β/γ) with the calculated molecular mass of 80 kDa, 70 kDa and 66 kDa, and apparent molecular mass of 100-110 kDa and 66-75 kDa (PMID: 18559665). This antibody is specific to FBXW7 and it can recognize all the isoforms of FBXW7.
发表文章
| Species | Application | Title |
|---|---|---|
Cell Cyclin E-induced replicative stress drives p53-dependent whole-genome duplication
| ||
iScience Polycomb repressive complex 2 binds and stabilizes NANOG to suppress differentiation-related genes to promote self-renewal | ||
Endocrinology Rictor regulates spermatogenesis by controlling Sertoli cell cytoskeletal organization and cell polarity in the mouse testis. | ||
Int J Biochem Cell Biol The deubiquitinase USP38 promotes cell proliferation through stabilizing c-Myc. |